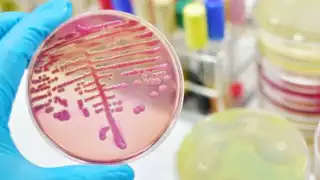
Klebsiella oxytoca: Esto es lo que sabe de la bacteria que le arrebató la vida a menores en Estado de México

La presidenta de México, Claudia Sheinbaum Pardo, enfatizó la necesidad de imponer sanciones en el caso de los niños fallecidos debido a la bacteria Klebsiella oxytoca en hospitales del Estado de México.
Durante la conferencia matutina en Palacio Nacional de este lunes 9 de diciembre, Sheinbaum destacó que las investigaciones continúan y que este martes la Secretaría de Salud federal brindará más detalles sobre el tema.
“La investigación está en marcha por parte de las instituciones de salud, además de lo que corresponde a la Fiscalía del Estado de México. Se trata de niños que recibieron alimentación intravenosa que presuntamente estaba contaminada”, explicó la mandataria.
Medidas preventivas y seguimiento
La mandataria informó que desde el inicio del brote se implementaron acciones preventivas. Entre estas, se suspendió el suministro del producto involucrado en hospitales de todo el país y la Comisión Federal para la Protección contra Riesgos Sanitarios (Cofepris) revocó el permiso para su distribución.

Noticia Destacada
Confirman 20 casos de niños Infectados por Klebsiella oxytoca en el Estado de México
“Siguiendo los protocolos, se emitieron alertas a nivel nacional y las investigaciones avanzan en varias frentes”, agregó.
El brote y sus implicaciones
La Secretaría de Salud confirmó el pasado sábado la detección de 20 casos de niños posiblemente infectados por la bacteria, 13 de los cuales lamentablemente fallecieron. Siete pacientes siguen bajo atención médica y, tras recibir tratamiento, sus cultivos resultaron negativos.
El brote, registrado en cuatro hospitales del Estado de México desde el 5 de diciembre, está asociado a una posible contaminación en soluciones de Nutrición Parenteral (NPT), utilizada para alimentar a los pacientes vía intravenosa.
Sheinbaum reiteró su compromiso de esclarecer los hechos y garantizar justicia para las familias afectadas. “Habrá sanciones para los responsables. La salud y seguridad de la población son prioridades para este gobierno”, puntualizó.
IO